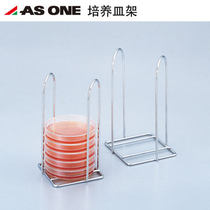
ASONE stainless steel glass petri dish rack for Φ75Φ90 experimental petri dish rack 304 stainless steel

1,286 similar products
 High quality burning Cup clamp 250mm with rubber sleeve burning Cup clamp with rubber sleeve iron plating
Price: $4.2146 Transactions
High quality burning Cup clamp 250mm with rubber sleeve burning Cup clamp with rubber sleeve iron plating
Price: $4.2146 Transactions
 Standard THGA graphite tube with end cap 20 package transverse heating Perkin Elmer B3000655
Price: $4,911.071 Transactions
Standard THGA graphite tube with end cap 20 package transverse heating Perkin Elmer B3000655
Price: $4,911.071 Transactions
 Glass mortar grinding Rod 6075 90mm research medicine mashing pot mashing bowl glass mortar grinding bowl
Price: $3.9530 Transactions
Glass mortar grinding Rod 6075 90mm research medicine mashing pot mashing bowl glass mortar grinding bowl
Price: $3.9530 Transactions
 BRAND automatic return to zero burette 15ml transparent bottle Prand automatic return to zero BRAND Burette
Price: $142.565 Transactions
BRAND automatic return to zero burette 15ml transparent bottle Prand automatic return to zero BRAND Burette
Price: $142.565 Transactions
 Standard port plug clip connecting clip plastic standard port clip taper interface clip plastic grinding hole clip
Price: $2.14958 Transactions
Standard port plug clip connecting clip plastic standard port clip taper interface clip plastic grinding hole clip
Price: $2.14958 Transactions
 Glass tube cutter ring blade ring blade glass test tube cutting knife blade
Price: $3.43107 Transactions
Glass tube cutter ring blade ring blade glass test tube cutting knife blade
Price: $3.43107 Transactions
 Glass surface 45 50 90 100 120 180mm beaker lid dish surface glass round dish 10 piece box
Price: $5.40102 Transactions
Glass surface 45 50 90 100 120 180mm beaker lid dish surface glass round dish 10 piece box
Price: $5.40102 Transactions
 Glass scale test tube 5 10 15 25 ml round bottom scale test tube culture test tube agglutination scale tube
Price: $2.39570 Transactions
Glass scale test tube 5 10 15 25 ml round bottom scale test tube culture test tube agglutination scale tube
Price: $2.39570 Transactions
 Huagou iodine flask 50 100 250 glass stopper iodine bottle fixed iodine flask
Price: $4.9579 Transactions
Huagou iodine flask 50 100 250 glass stopper iodine bottle fixed iodine flask
Price: $4.9579 Transactions
 ASONE Japanese imported ASONE flat with dragon head pot 10L 20L with PP faucet flat square dragon head pot
Price: $32.1115 Transactions
ASONE Japanese imported ASONE flat with dragon head pot 10L 20L with PP faucet flat square dragon head pot
Price: $32.1115 Transactions
 Imported organic solvent sprayer 500ml spray pot enhanced pp plastic spray cleaning bottle
Price: $42.152 Transactions
Imported organic solvent sprayer 500ml spray pot enhanced pp plastic spray cleaning bottle
Price: $42.152 Transactions
 Stainless steel wire taper interface clamp standard steel wire marking clamp standard grinding port clamp
Price: $3.3020 Transactions
Stainless steel wire taper interface clamp standard steel wire marking clamp standard grinding port clamp
Price: $3.3020 Transactions
 ASONE slide holder can put 20 pieces of stainless steel SUS304 imported slide holder 2-162-01
Price: $13.8312 Transactions
ASONE slide holder can put 20 pieces of stainless steel SUS304 imported slide holder 2-162-01
Price: $13.8312 Transactions
 ASONE slide angle 90 ° edge polished 25 * 75mm 50 pieces of box Azovang imported slide
Price: $8.3522 Transactions
ASONE slide angle 90 ° edge polished 25 * 75mm 50 pieces of box Azovang imported slide
Price: $8.3522 Transactions
 ASONE stainless steel glass petri dish rack for Φ75Φ90 experimental petri dish rack 304 stainless steel
Price: $38.1314 Transactions
ASONE stainless steel glass petri dish rack for Φ75Φ90 experimental petri dish rack 304 stainless steel
Price: $38.1314 Transactions
 Imported ESCO leak detector 100ml with brush EA704D stomatal detection fluid crack leak detector
Price: $16.048 Transactions
Imported ESCO leak detector 100ml with brush EA704D stomatal detection fluid crack leak detector
Price: $16.048 Transactions
 Cai En Cup No. 2 Cup 1 3 4 5 Cup Chai's Cup zahn Cup immersion viscosity cup BGD viscosity cup
Price: $82.9846 Transactions
Cai En Cup No. 2 Cup 1 3 4 5 Cup Chai's Cup zahn Cup immersion viscosity cup BGD viscosity cup
Price: $82.9846 Transactions
 ASONE imported lenticular paper 100 * 150mm advanced lens paper 100 sheets This microscope camera lens wipe
Price: $5.9022 Transactions
ASONE imported lenticular paper 100 * 150mm advanced lens paper 100 sheets This microscope camera lens wipe
Price: $5.9022 Transactions
 Bunsen burner gas burner gas burner laboratory burner for multi-purpose burner detachable burner tripod
Price: $6.7182 Transactions
Bunsen burner gas burner gas burner laboratory burner for multi-purpose burner detachable burner tripod
Price: $6.7182 Transactions
 Tetrafluoride reagent bottle 150ml PTFE reagent bottle PTFE reagent bottle F4 reagent bottle solvent bottle
Price: $39.02100 Transactions
Tetrafluoride reagent bottle 150ml PTFE reagent bottle PTFE reagent bottle F4 reagent bottle solvent bottle
Price: $39.02100 Transactions
 Tickets BGD pygth Cup 50mL 100mLBGD paint pygmy stainless steel pygmy density Cup
Price: $80.0859 Transactions
Tickets BGD pygth Cup 50mL 100mLBGD paint pygmy stainless steel pygmy density Cup
Price: $80.0859 Transactions
 30-hole plexiglass storage bottle holder for 20 30 40 60ML EPA sample bottle holder empty bottle holder
Price: $13.3629 Transactions
30-hole plexiglass storage bottle holder for 20 30 40 60ML EPA sample bottle holder empty bottle holder
Price: $13.3629 Transactions
 ASONE plastic sprayer can be autoclaved 500ml imported Azovang plastic spray bottle spray bottle
Price: $45.055 Transactions
ASONE plastic sprayer can be autoclaved 500ml imported Azovang plastic spray bottle spray bottle
Price: $45.055 Transactions

Facebook
Facebook Pinterest
Pinterest Twitter
Twitter